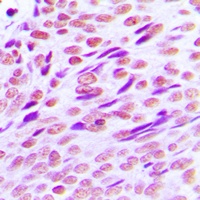
产品细节图片2

相关产品推荐更多 >
万千商家帮你免费找货
0 人在求购买到急需产品
- 详细信息
- 文献和实验
- 技术资料
- 抗体名:
CTBP2 Antibody [KO/KD Validated]抗体
- 抗体英文名:
CTBP2 Antibody [KO/KD Validated]
- 应用范围:
IF, IHC, WB
- 宿主:
Rabbit
- 适应物种:
Bovine, Human, Mouse, Rat
- 保质期:
6-12个月
- 抗原来源:
详询
- 目录编号:
orb216079
- 级别:
科研级
- 库存:
88
- 供应商:
biorbyt
- 标记物:
Unconjugated
- 克隆性:
Polyclonal
- 形态:
Liquid in 0.42% Potassium phosphate, 0.87% Sodium chloride, pH 7.3, 30% glycerol, and 0.01% sodium azide.
- 免疫原:
KLH-conjugated synthetic peptide encompassing a sequence within the C-term region of human CTBP2. The exact sequence is proprietary.
- 规格:
30 ul
别名:C-terminal-binding protein 2; CtBP2
免疫原:KLH-conjugated synthetic peptide encompassing a sequence within the C-term region of human CTBP2. The exact sequence is proprietary.
应用稀释比例:WB: 1:500-1:1000, IHC-P: 1:100-1-200, IF/ICC: 1:100-1:500
纯化:The antibody was purified by immunogen affinity chromatography.
保存说明:Maintain refrigerated at 2-8°C for up to 2 weeks. For long term storage store at -20°C in small aliquots to prevent freeze-thaw cycles.
Entrez:1488, 81717, 13017
UniProt ID:P56546, Q9EQH5, P56545
Note:For research use only.

风险提示:丁香通仅作为第三方平台,为商家信息发布提供平台空间。用户咨询产品时请注意保护个人信息及财产安全,合理判断,谨慎选购商品,商家和用户对交易行为负责。对于医疗器械类产品,请先查证核实企业经营资质和医疗器械产品注册证情况。
文献和实验糖,建议进行 Pre-clear;如果使用磁珠,此步可忽略 抗 X 抗体的轻链(25 kD)和重链(50 kD) 更侧重于如何在实验上进行优化(见下文) *注意:总蛋白上样量过多也会造成 非特异性结合,建议上样量为 500 ug-1 mg。上样之前一定要先用 BCA 定个量!定个量!定个量! pre-clear:上样前先用裂解液过一遍柱子,减少基质本身对蛋白的吸附 Output:在某些 co-IP 实验中,实验人员会把IP后的上清分别进行诱饵蛋白 X 和靶蛋白 Y 的 WB 检测
band-shifts; . Band-shift assay for the determination of Kd Determination of the concentration of radiolabeled antibody In parallel tubes, incubate a ‰ 1 µM radiolabeled antibody solution in PBS with increasing concentrations
Whole genome amplification protocol for ChIP-chip
of different factors (E2F family members, KAP1, CtBP2, ZNF217) as well as on histone modifications (H3me3K9, H3me3K27, H3me3K4) (Krig et al., 2007; O'Geen et al., 2007). Another benefit of the WGA amplification method is the ability to perform a second
技术资料暂无技术资料 索取技术资料











